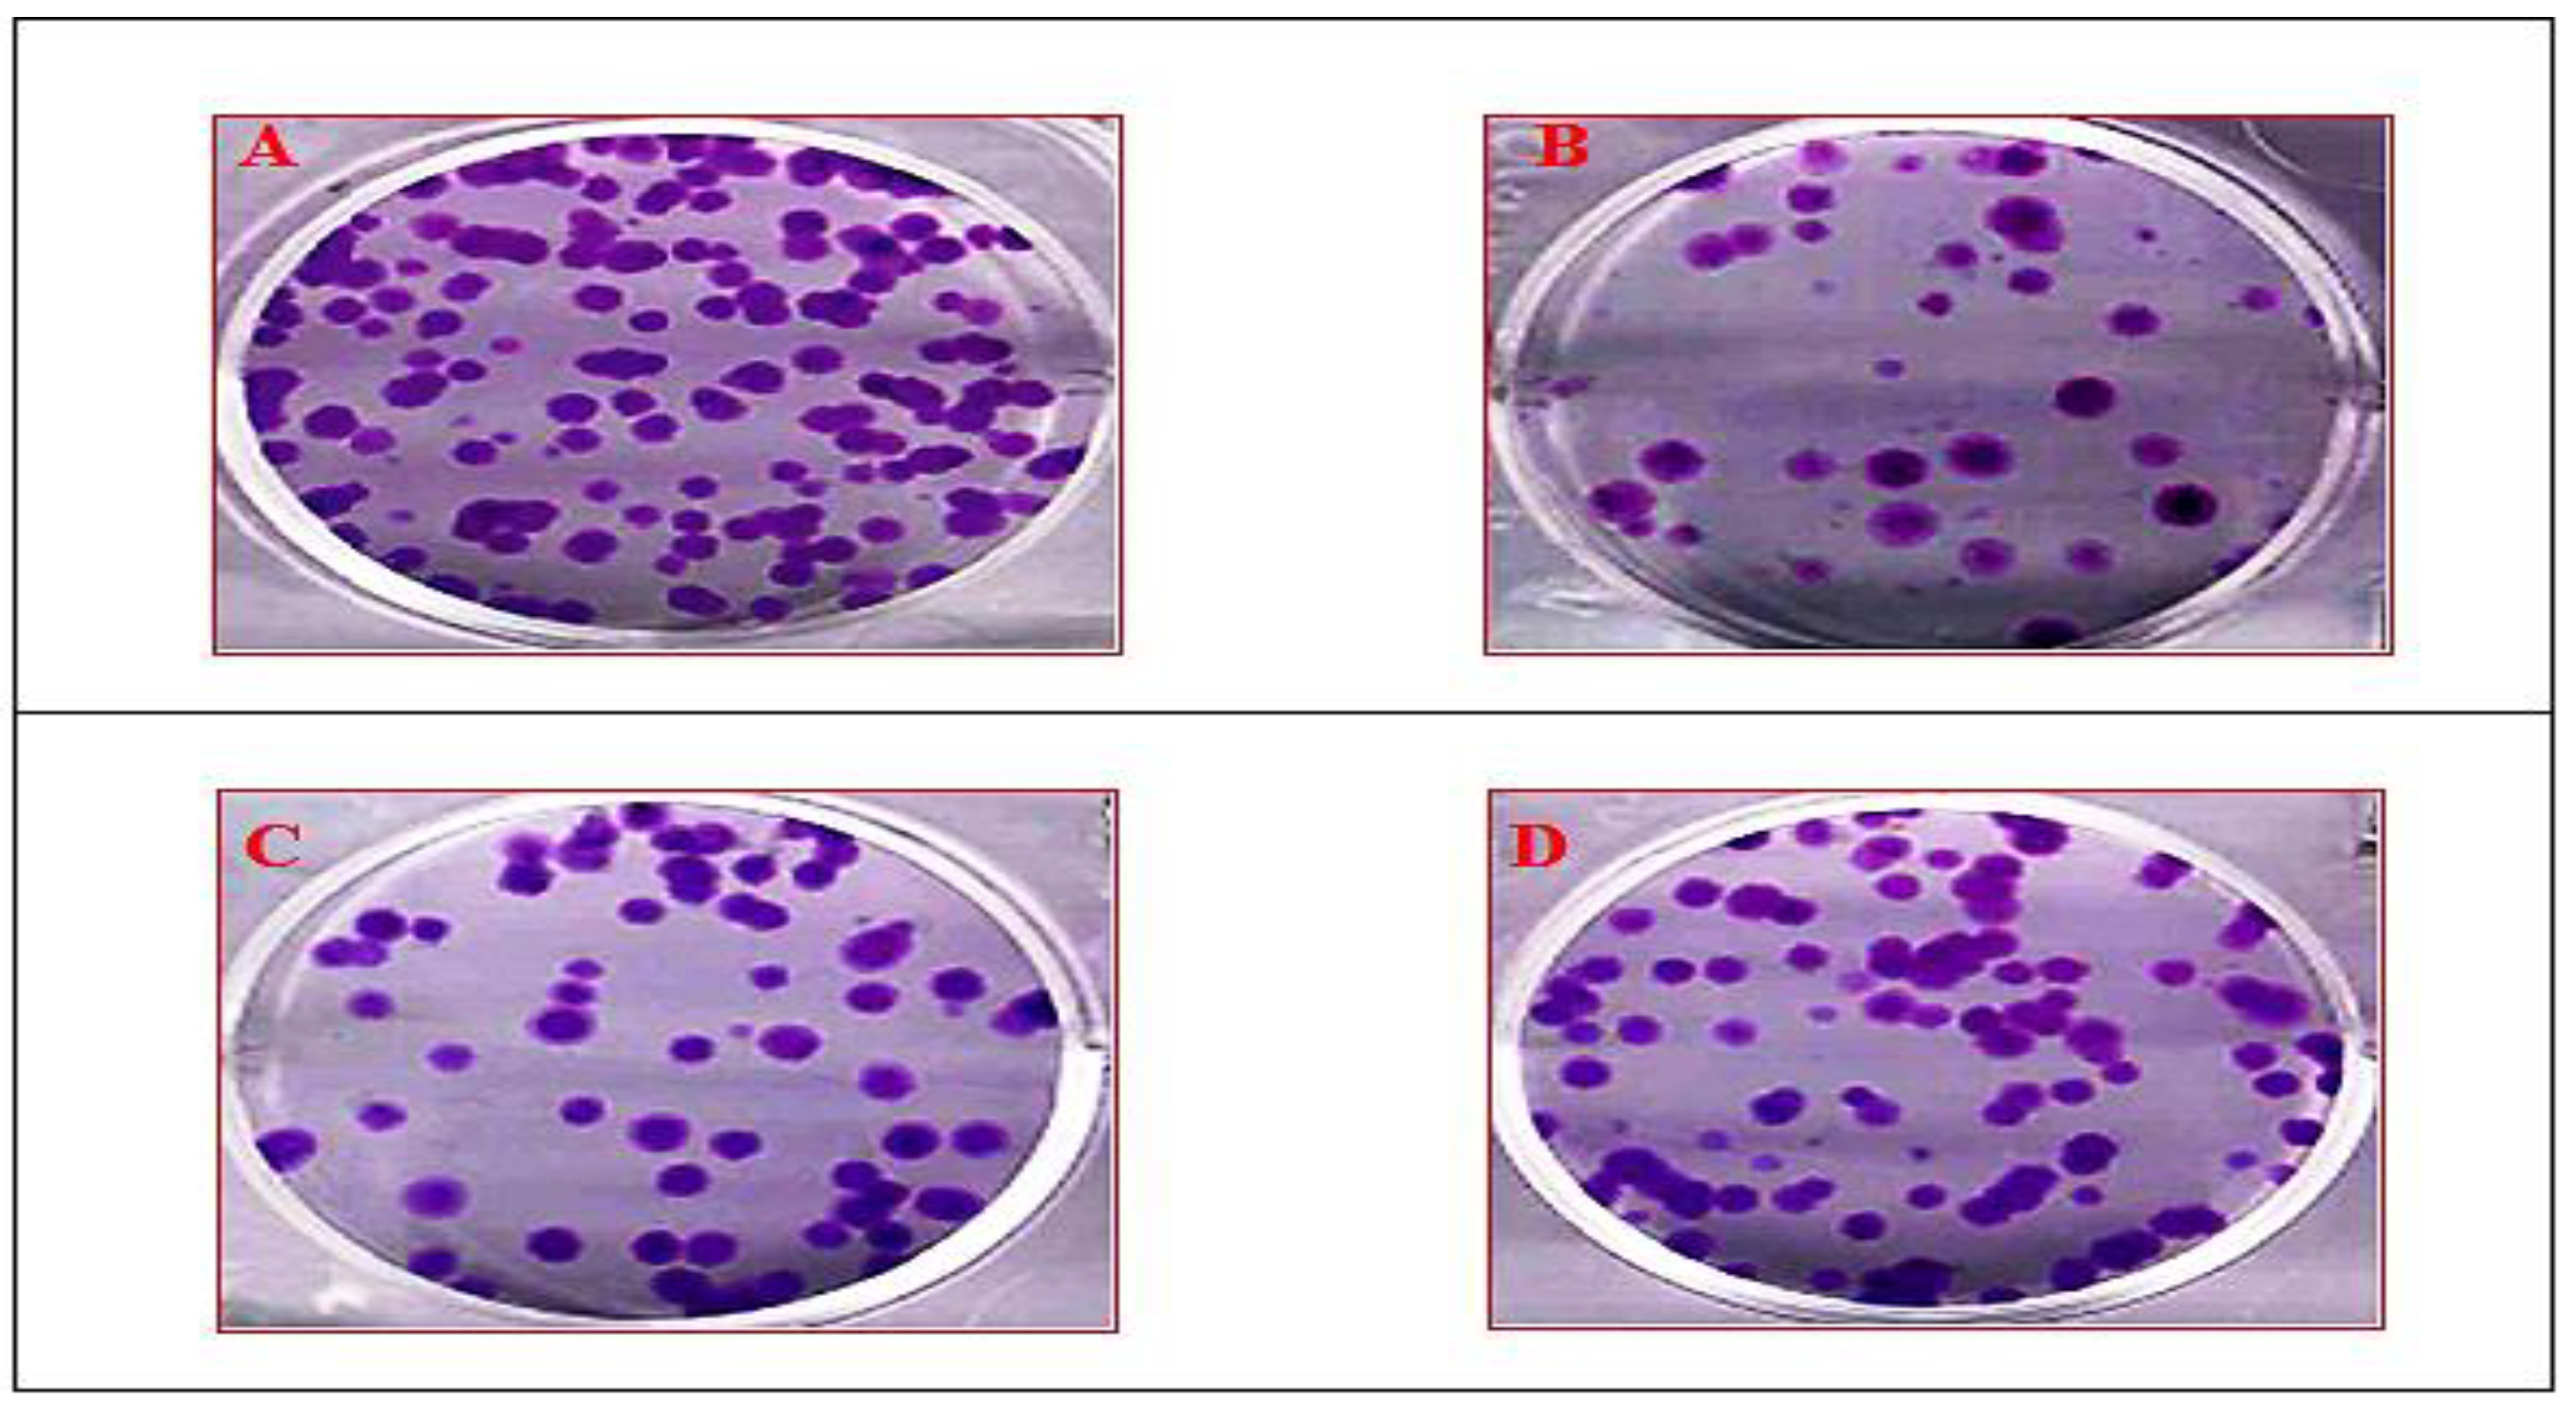
Antioxidants 10 00934 g007

Pharmacological Potentiality of Bioactive Flavonoid against Ketamine Induced Cell Death of PC 12 Cell Lines: An In Vitro Study
Abstract
1. Introduction
2. Materials and Methods
2.1. Procurement of Chemicals
2.2. Source of Plant Constituent and Cell Lines
2.3. Toxicity Studies
2.4. Experimental Design (In Vitro)
2.5. Determination of Tissue Culture Inhibitory Concentration (IC50)
2.6. Determination of Tissue Culture Effective Concentration (EC50)
2.7. MTT Assay
2.8. LDH Assay
2.9. DCFH-DA Assay
2.10. Clonogenic Assay
2.11. Isolation of RNA
2.12. Complementary DNA Synthesis (cDNA)
2.13. Polymerase Chain Reaction of cDNA Synthesized Groups
2.14. Densitometric Analysis
2.15. Statistical Analysis
3. Results
3.1. Determination of Tissue Culture Inhibitory Concentration of Ketamine, Effective Concentration of Clozapine and Compound
3.2. Cytotoxicity of the Compound by MTT Assay
3.3. Lactate Dehydrogenase (LDH) Assay
3.4. Measurement of Intracellular ROS
3.5. Clonogenic Assay
3.6. Semi-Quantitative RT-PCR Analysis
3.7. Densitometric Analysis
4. Discussion
5. Conclusions
6. Significance Statements
Author Contributions
Funding
Institutional Review Board Statement
Informed Consent Statement
Data Availability Statement
Acknowledgments
Conflicts of Interest
References
- Li, X.-X.; He, G.R.; Mu, X.; Xu, B.; Tian, S.; Yu, X.; Du, G.-H. Protective effects of baicalein against rotenone-induced neurotoxicity in PC 12 cells and isolated rat brain mitochondria. Eur. J. Pharmacol. 2012, 674, 227–233. [Google Scholar] [CrossRef]
- Shi, L.-L.; Qiang, G.-F.; Gao, M.; Zhang, H.-A.; Chen, B.-N.; Yu, X.-Y.; Du, G.-H. Effect of pinocembrin on brain mitochondrial respiratory function. Acta Pharm. Sin. 2011, 46, 642–649. [Google Scholar]
- Guang, H.-M.; Du, G.-H. Protections of pinocembrin on brain mitochondria contribute to cognitive improvement in chronic cerebral hypoperfused rats. Eur. J. Pharmacol. 2006, 542, 77–83. [Google Scholar] [CrossRef]
- Habtemariam, S. Rutin as a natural therapy for Alzheimer’s disease: Insights into its mechanisms of action. Curr. Med. Chem. 2016, 23, 860–873. [Google Scholar] [CrossRef] [PubMed]
- Regitz, C.; Marie Dußling, L.; Wenzel, U. Amyloid-beta (A β1-42)-induced paralysis in Caenorhabditis elegans is inhibited by the polyphenol quercetin through activation of protein degradation pathways. Mol. Nutr. Food Res. 2014, 58, 1931–1940. [Google Scholar] [CrossRef] [PubMed]
- Qu, L.; Liang, X.; Gu, B.; Liu, W. Quercetin alleviates high glucose-induced Schwann cell damage by autophagy. Neural Regen. Res. 2014, 9, 1195. [Google Scholar] [CrossRef]
- Zhu, G.; Wang, X.; Wu, S.; Li, Q. Involvement of activation of PI3K/Akt pathway in the protective effects of puerarin against MPP+-induced human neuroblastoma SH-SY5Y cell death. Neurochem. Int. 2012, 60, 400–408. [Google Scholar] [CrossRef]
- Zhou, Y.; Xie, N.; Li, L.; Zou, Y.; Zhang, X.; Dong, M. Puerarin alleviates cognitive impairment and oxidative stress in APP/PS1 transgenic mice. Int. J. Neuropsychopharmacol. 2014, 17, 635–644. [Google Scholar] [CrossRef]
- Li, L.; Xue, Z.; Chen, L.; Chen, X.; Wang, H.; Wang, X. Puerarin suppression of Aβ1-42-induced primary cortical neuron death is largely dependent on ERβ. Brain Res. 2017, 1657, 87–94. [Google Scholar] [CrossRef] [PubMed]
- Tang, H.; Song, X.; Ling, Y.; Wang, X.; Yang, P.; Luo, T.; Chen, A. Puerarin attenuates myocardial hypoxia/reoxygenation injury by inhibiting autophagy via the Akt signaling pathway. Mol. Med. Rep. 2017, 15, 3747–3754. [Google Scholar] [CrossRef] [PubMed]
- Pandy, V.; Narasingam, M.; Mohamed, Z. Antipsychotic-like activity of noni (Morinda citrifolia Linn.) in mice. BMC Complementary Altern. Med. 2012, 12, 186. [Google Scholar] [CrossRef]
- Zhang, Z.-J. Therapeutic effects of herbal extracts and constituents in animal models of psychiatric disorders. Life Sci. 2004, 75, 1659–1699. [Google Scholar] [CrossRef] [PubMed]
- Bigoniya, P.; Rana, A.-C. Psychopharmacological profile of hydro-alcoholic extract of Euphorbia neriifolia leaves in mice and rats. Indian J. Exp. Biol. 2005, 43, 859–862. [Google Scholar]
- Kothari, S.; Minda, M.; Tonpay, S.-D. Anxiolytic and antidepressant activities of methanol extract of Aegle marmelos leaves in mice. Indian J. Physiol. Pharmacol. 2010, 54, 318–328. [Google Scholar] [PubMed]
- Chintha, V.; Wudayagiri, R. Isolation and neuroprotective prospective of novel bioactive compound “3-(3,4-dimethoxyphenyl)-1-(4-methoxyphenyl) prop-2-en-1-one” against ketamine-induced cognitive deficits in schizophrenia: An experimental study. Nat. Prod. Res. 2021, 1, 1–6. [Google Scholar] [CrossRef] [PubMed]
- Venkataramaiah, C.; Lakshmi Priya, B.; Rajendra, W. Perturbations in the catecholamine metabolism and protective effect of “3-(3, 4-dimethoxy phenyl)-1-4 (methoxy phenyl) prop-2-en-1-one” during ketamine-induced schizophrenia: An in vivo and in silico studies. J. Biomol. Struct. Dyn. 2020, 1–10. [Google Scholar] [CrossRef] [PubMed]
- Venkataramaiah, C.; Payani, S.; Priya, B.-L.; Pradeepkiran, J.-A. Therapeutic potentiality of a new flavonoid against ketamine induced glutamatergic dysregulation in schizophrenia: In vivo and in silico approach. Biomed. Pharmacother. 2021, 138, 111453. [Google Scholar] [CrossRef]
- Venkataramaiah, C. Modulations in the ATPases during ketamine-induced schizophrenia and regulatory effect of “3-(3, 4-dimethoxy phenyl)-1-(4-methoxyphenyl) prop-2-en-1-one”: An in vivo and in silico studies. J. Recept. Signal Transduct. 2020, 40, 148–156. [Google Scholar] [CrossRef]
- Bai, O.; Wei, Z.; Lu, W.; Bowen, R.; Keegan, D.; Li, X.-M. Protective effects of atypical antipsychotic drugs on PC12 cells after serum withdrawal. J. Neurosci. Res. 2002, 69, 278–283. [Google Scholar] [CrossRef]
- Wei, Z.-L.; Li, X. Neuroprotective effects of some atypical antipsychotics. Fifth Alz Park Dis Abstr 2001, 104. [Google Scholar]
- Lin, C.-M.; Lin, Y.-T.; Lee, T.-L.; Imtiyaz, Z.; Hou, W.-C.; Lee, M.-H. In vitro and in vivo evaluation of the neuroprotective activity of Uncaria hirsuta Haviland. J. Food Drug Anal. 2020, 28, 147–158. [Google Scholar] [CrossRef] [PubMed]
- Lundberg, M.; Curbo, S.; Bohman, H.; Agartz, I.; Ögren, S.-O.; Patrone, C.; Mansouri, S. Clozapine protects adult neural stem cells from ketamine-induced cell death in correlation with decreased apoptosis and autophagy. Biosci. Rep. 2020, 40, 135–146. [Google Scholar] [CrossRef]
- Kumar, P.; Nagarajan, A.; Uchil, P.-D. Analysis of cell viability by the MTT assay. Cold Spring Harb. Protoc. 2018, 6, 095505. [Google Scholar] [CrossRef]
- Soyingbe, O.-S.; Mongalo, N.-I.; Makhafola, T.J. In vitro antibacterial and cytotoxic activity of leaf extracts of Centella asiatica (L.) Urb, Warburgia salutaris (Bertol. F.) Chiov and Curtisia dentata (Burm. F.) CA Sm-medicinal plants used in South Africa. BMC Complementary Altern. Med. 2018, 18, 1–10. [Google Scholar] [CrossRef] [PubMed]
- Heo, J.-R.; Lee, G.-A.; Kim, G.-S.; Hwang, K.-A.; Choi, K.-C. Phytochemical-induced reactive oxygen species and endoplasmic reticulum stress-mediated apoptosis and differentiation in malignant melanoma cells. Phytomedicine 2018, 39, 100–110. [Google Scholar] [CrossRef]
- McDonald, M.; Corde, S.; Lerch, M.; Rosenfeld, A.; Jackson, M.; Tehei, M. First in vitro evidence of modulated electro-hyperthermia treatment performance in combination with megavoltage radiation by clonogenic assay. Sci. Rep. 2018, 8, 1–13. [Google Scholar] [CrossRef]
- Villa-Rodríguez, E.; Ibarra-Gámez, C.; de los Santos-Villalobos, S. Extraction of high-quality RNA from Bacillus subtilis with a lysozyme pre-treatment followed by the Trizol method. J. Microbiol. Methods 2018, 147, 14–16. [Google Scholar] [CrossRef] [PubMed]
- Suzuki, T.; Ikeda, H.; Mase, M. Restricted viral cDNA synthesis in cell lines that fail to support productive infection by bovine leukemia virus. Arch. Virol. 2018, 163, 2415–2422. [Google Scholar] [CrossRef] [PubMed]
- Rebelo, A.-R.; Bortolaia, V.; Kjeldgaard, J.-S.; Pedersen, S.-K.; Leekitcharoenphon, P.; Hansen, I.-M.; Battisti, A. Multiplex PCR for detection of plasmid-mediated colistin resistance determinants, mcr-1, mcr-2, mcr-3, mcr-4 and mcr-5 for surveillance purposes. Eurosurveillance 2018, 23, 17-00672. [Google Scholar] [CrossRef]
- Rasband, W.-S. ImageJ.; National Institutes of Health: Bethesda, MD, USA, 2018. Available online: https://imagej.nih.gov/ij/ (accessed on 7 June 2021).
- Youdim, K.-A.; Spencer, J.-P.; Schroeter, H.; Rice-Evans, C. Dietary flavonoids as potential neuroprotectants. Biol. Chem. 2001, 383, 503–519. [Google Scholar] [CrossRef]
- Inanami, O.; Watanabe, Y.; Syuto, B.; Nakano, M.; Tsuji, M.; Kuwabara, M. Oral administration of (-) catechin protects against ischemia-reperfusion-induced neuronal death in the gerbil. Free Radic. Res. 1998, 29, 359–365. [Google Scholar] [CrossRef]
- Luo, Y.; Smith, J.-V.; Paramasivam, V.; Burdick, A.; Curry, K.-J.; Buford, J.-P.; Butko, P. Inhibition of amyloid-β aggregation and caspase-3 activation by the Ginkgo biloba extract EGb761. Proc. Natl. Acad. Sci. USA 2002, 99, 12197–12202. [Google Scholar] [CrossRef]
- Bastianetto, S.; Zheng, W.-H.; Quirion, R. The Ginkgo biloba extract (EGb 761) protects and rescues hippocampal cells against nitric oxide-induced toxicity: Involvement of its flavonoid constituents and protein kinase C. J. Neurochem. 2000, 74, 2268–2277. [Google Scholar] [CrossRef]
- Datla, K.-P.; Christidou, M.; Widmer, W.-W.; Rooprai, H.-K.; Dexter, D.-T. Tissue distribution and neuroprotective effects of citrus flavonoid tangeretin in a rat model of Parkinson’s disease. Neuroreport 2001, 12, 3871–3875. [Google Scholar] [CrossRef] [PubMed]
- Jellinger, K.-A. Cell death mechanisms in neurodegeneration. J. Cell. Mol. Med. 2001, 5, 1–17. [Google Scholar] [CrossRef] [PubMed]
- Slikker, W.; Liu, F.; Rainosek, S.-W.; Patterson, T.-A.; Sadovova, N.; Hanig, J.-P.; Wang, C. Ketamine-induced toxicity in neurons differentiated from neural stem cells. Mol. Neurobiol. 2015, 52, 959–969. [Google Scholar] [CrossRef]
- Wu, Y.-Q.; Liang, T.; Huang, H.; Zhu, Y.-Z.; Zhao, P.-P.; Xu, C.-M.; Zhou, C.-H. Ketamine inhibits proliferation of neural stem cell from neonatal rat hippocampus in vitro. Cell. Physiol. Biochem. 2014, 34, 1792–1801. [Google Scholar] [CrossRef]
- Nehar, D.; Mauduit, C.; Boussouar, F.; Benahmed, M. Interleukin 1α stimulates lactate dehydrogenase A expression and lactate production in cultured porcine Sertoli cells. Biol. Reprod. 1998, 59, 1425–1432. [Google Scholar] [CrossRef]
- Wolterbeek, H.-T.; Van der Meer, A.-J. Optimization, application, and interpretation of lactate dehydrogenase measurements in micro well determination of cell number and toxicity. Assay Drug Dev. Technol. 2005, 3, 675–682. [Google Scholar] [CrossRef]
- Tan, S.; Lam, W.-P.; Wai, M.-S.; Yu, W.-H.-A.; Yew, D.-T. Chronic ketamine administration modulates midbrain dopamine system in mice. PLoS ONE 2012, 7, e43947. [Google Scholar] [CrossRef] [PubMed]
- Wang, C.; Sadovova, N.; Fu, X.; Schmued, L.; Scallet, A. The role of the N-methyl-D-aspartate receptor in ketamine-induced apoptosis in rat forebrain culture. Neuroscience 2005, 132, 967–977. [Google Scholar] [CrossRef] [PubMed]
- Rothman, D.L.; Behar, K.; Hetherington, H.P.; Hollander, J.A.D.; Bendall, M.R.; Petroff, O.A.; Shulman, R.G. 1H-Observe/13C-decouple spectroscopic measurements of lactate and glutamate in the rat brain in vivo. Proc. Natl. Acad. Sci. USA 1985, 82, 1633–1637. [Google Scholar] [CrossRef] [PubMed]
- Lee, S.-T.; Wu, T.-T.; Yu, P.-Y.; Chen, R.-M. Apoptotic insults to human HepG2 cells induced by S-(+)-ketamine occurs through activation of a Bax-mitochondria-caspase protease pathway. Br. J. Anesthesiol. 2009, 102, 80–89. [Google Scholar] [CrossRef]
- Wang, C.; Sadovova, N.; Hotchkis, C.; Fu, X.; Scallet, A.-C. Blockade of N-methyl-D-aspartate receptors by ketamine produces loss of postnatal day 3 monkey frontal cortical neurons in culture. Toxicol. Sci. 2006, 91, 192–201. [Google Scholar] [CrossRef] [PubMed]
- Okamoto, T.; Okutani, R.; Tashiro, C. The dual effect of ketamine on dopamine release from rat pheochromocytoma (PC-12) cells. Masui 1996, 45, 1083–1087. [Google Scholar]
- Spencer, J.P. The interactions of flavonoids within neuronal signalling pathways. Genes Nutr. 2007, 2, 257–273. [Google Scholar] [CrossRef]
- Williams, R.-J.; Spencer, J.-P.; Rice-Evans, C. Flavonoids: Antioxidants or signalling molecules? Free Radic. Biol. Med. 2004, 36, 838–849. [Google Scholar] [CrossRef]
- Spencer, J.-P.; Schroeter, H.; Crossthwaithe, A.-J.; Kuhnle, G.; Williams, R.-J.; Rice-Evans, C. Contrasting influences of glucuronidation and O-methylation of epicatechin on hydrogen peroxide-induced cell death in neurons and fibroblasts. Free Radic. Biol. Med. 2001, 31, 1139–1146. [Google Scholar] [CrossRef]
- Flatmark, T.; Stevens, R.-C. Structural insight into the aromatic amino acid hydroxylases and their disease-related mutant forms. Chem. Rev. 1999, 99, 2137–2160. [Google Scholar] [CrossRef]
- Du Bois, T.-M.; Hsu, C.-W.; Li, Y.; Tan, Y.-Y.; Deng, C.; Huang, X.-F. Altered dopamine receptor and dopamine transporter binding and tyrosine hydroxylase mRNA expression following perinatal NMDA receptor blockade. Neurochem. Res. 2008, 33, 1224–1231. [Google Scholar] [CrossRef]
- Hons, J.; Zirko, R.; Ulrychova, M.; Cermakova, E.; Doubek, P.; Libiger, J. Glycine serum level in schizophrenia: Relation to negative symptoms. Psychiatry Res. 2010, 176, 103–108. [Google Scholar] [CrossRef] [PubMed]

| Concentration (µg/mL) | % of Cell Viability with SD |
|---|---|
| 10 | 50.40 ± 2.23 *# |
| 20 | 48.63 ± 1.20 * |
| 30 | 39.25 ± 1.61 * |
| 40 | 31.05 ± 1.88 * |
| 50 | 14.10 ± 1.20 * |
| Control Cells | 100 ± 2.24 |
Publisher’s Note: MDPI stays neutral with regard to jurisdictional claims in published maps and institutional affiliations. |
© 2021 by the authors. Licensee MDPI, Basel, Switzerland. This article is an open access article distributed under the terms and conditions of the Creative Commons Attribution (CC BY) license (https://creativecommons.org/licenses/by/4.0/).
Share and Cite
Venkataramaiah, C.; Priya, B.L.; Payani, S.; Pradeepkiran, J.A. Pharmacological Potentiality of Bioactive Flavonoid against Ketamine Induced Cell Death of PC 12 Cell Lines: An In Vitro Study. Antioxidants 2021, 10, 934. https://doi.org/10.3390/antiox10060934
Venkataramaiah C, Priya BL, Payani S, Pradeepkiran JA. Pharmacological Potentiality of Bioactive Flavonoid against Ketamine Induced Cell Death of PC 12 Cell Lines: An In Vitro Study. Antioxidants. 2021; 10(6):934. https://doi.org/10.3390/antiox10060934
Chicago/Turabian StyleVenkataramaiah, Chintha, Bandila Lakshmi Priya, Sholapuri Payani, and Jangampalli Adi Pradeepkiran. 2021. "Pharmacological Potentiality of Bioactive Flavonoid against Ketamine Induced Cell Death of PC 12 Cell Lines: An In Vitro Study" Antioxidants 10, no. 6: 934. https://doi.org/10.3390/antiox10060934
APA StyleVenkataramaiah, C., Priya, B. L., Payani, S., & Pradeepkiran, J. A. (2021). Pharmacological Potentiality of Bioactive Flavonoid against Ketamine Induced Cell Death of PC 12 Cell Lines: An In Vitro Study. Antioxidants, 10(6), 934. https://doi.org/10.3390/antiox10060934

